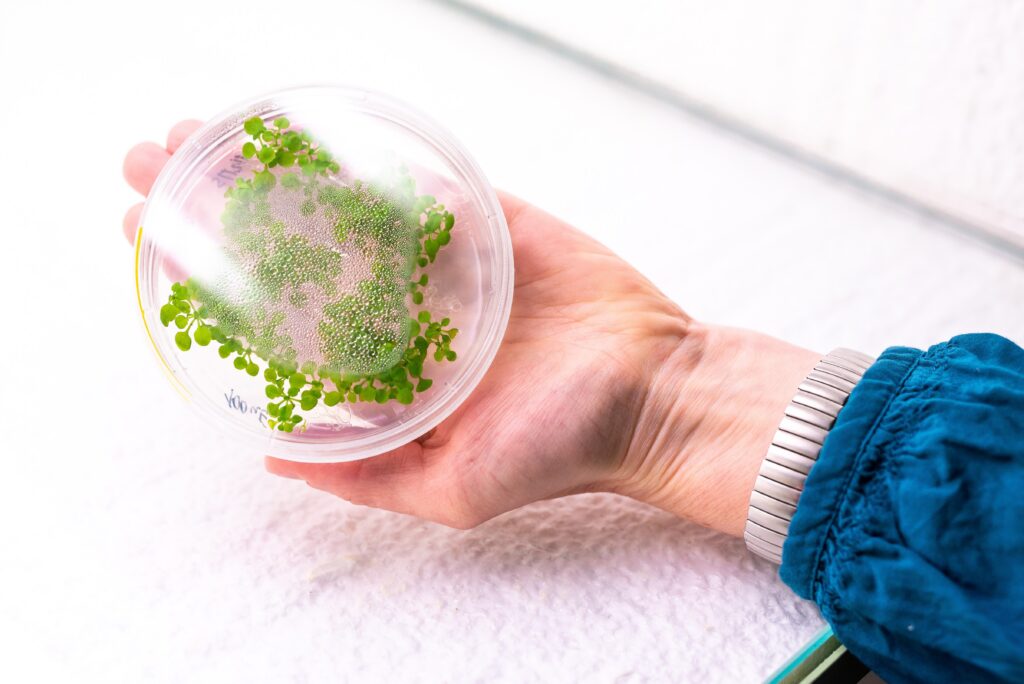

FAIR Principles
These principles were developed as an international standard for the responsible management of research data and today serve as the guiding recommendations for most funding agencies, universities, and data infrastructures.
FAIR data is data that is designed and processed in a way that makes it easy to find, access, integrate with other data, and reuse by people and computers. The goal of FAIR is not necessarily “maximum openness,” but rather ensuring that data is valuable and usable
„as open as possible, as closed as necessary“.
Well-managed data does more than just increase transparency. It significantly enhances the reproducibility of research, reduces the risk of data loss, and enables the reuse of data in other projects. FAIR is not synonymous with Open Data. Data can be FAIR while remaining non-public, provided there are clear access rules in place.
FAIR does not mean the same thing as OPEN

Open data is data that is publicly available online without any major restrictions. Users can freely download, reuse, combine with other data sets and distribute it. The ideal standard is that open data is also managed according to the FAIR principles. However, data that is not fully documented or structured according to FAIR can also be considered open if there is unrestricted access to it.
FAIR data is data that meets four key principles (read below). FAIR therefore refers to the way in which data is managed and documented. FAIR data can be publicly available, but this is not a condition: under certain circumstances, they can be FAIR even if access is restricted, for example for reasons of personal data protection, trade secrets, state security. technology transfer, etc.
4 PILLARS

Findable
Provide persistent identifiers (DOI, Handle), a set of descriptive metadata, and indexing by a repository or catalogue. Metadata should be machine-readable. Benefit: others (including search engines and services) can find your data without having to contact the author.

Accessible
Data should be accessible via an open protocol and free of charge. If data must remain restricted (e.g. due to commercial restrictions, GDPR, state security), metadata must be available and procedures for gaining access (request, embargo, contract) must be published.

Interoperable
Use open, common formats, standardized vocabularies/ontologies, and clearly defined metadata (disciplinary schemas where they exist). This allows the data to be combined with other datasets and used in further research

Reusable
Provide full information about the origin of the data, collection methodology, version, quality, etc. Publish it with a clear and accessible license (e.g. CC-BY). Accurate and detailed documentation and appropriate licenses maximize the reusability of the data and thus the citation of your research.
